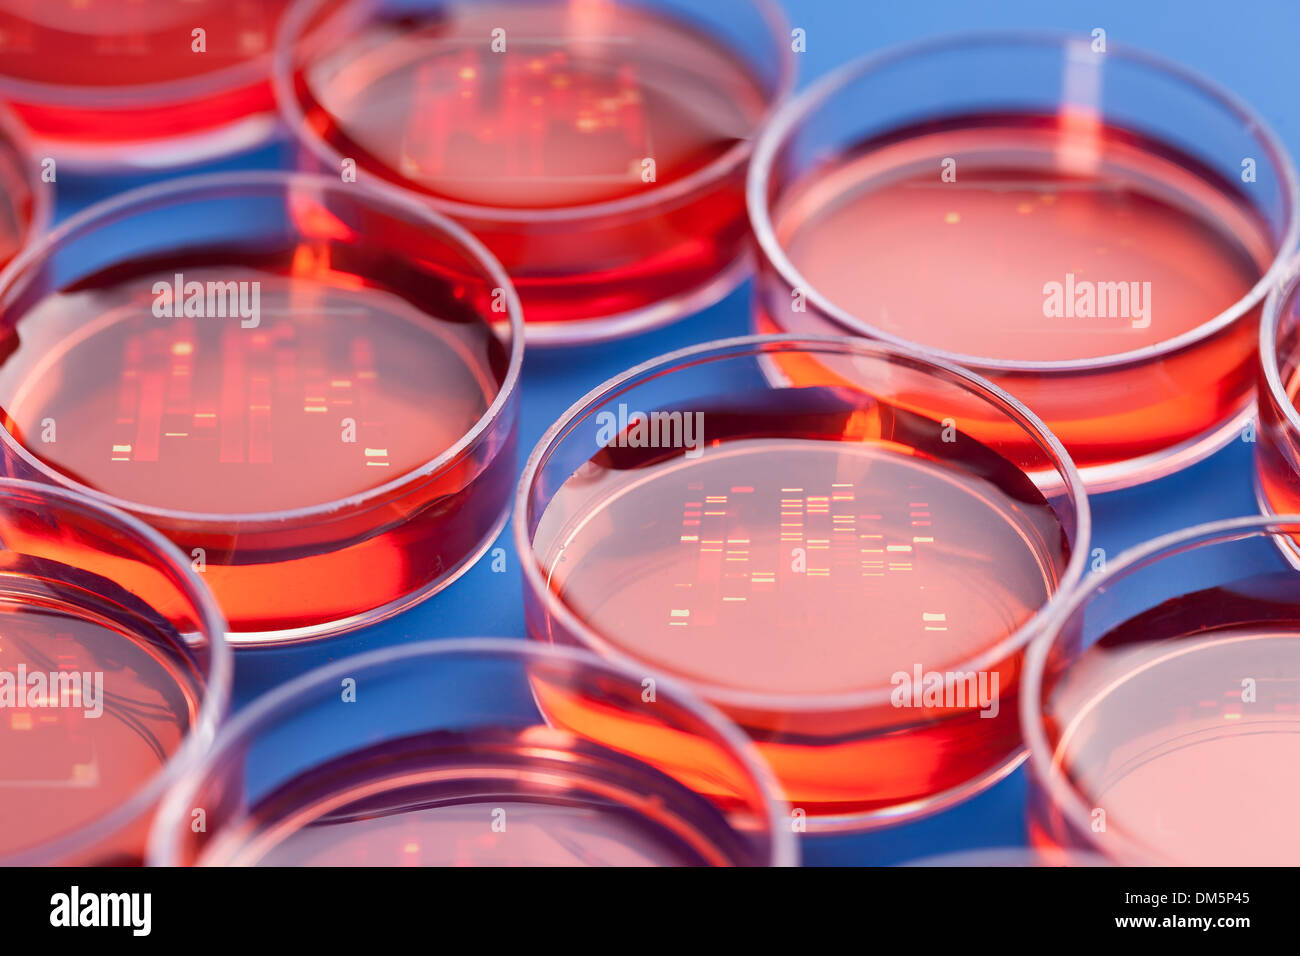
Pétri avec des échantillons pour le séquençage d'ADN Banque D'Images
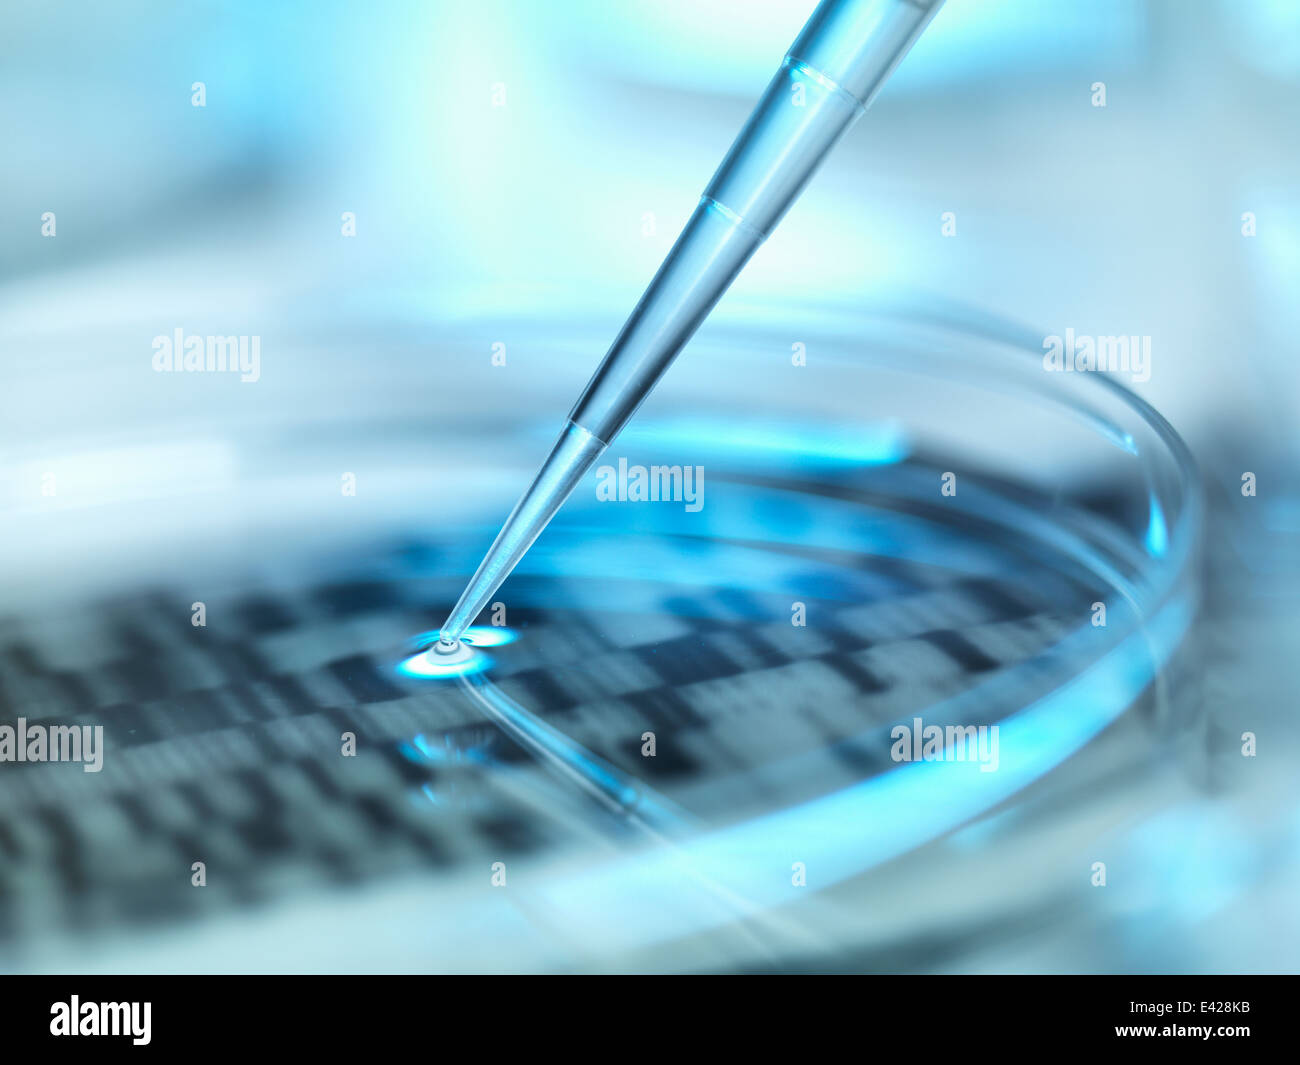
L'ADN (acide désoxyribonucléique) autoradiogram dans une boîte de pétri Banque D'Images

Dna sequencing Photos Stock & Des Images
(5,694)Filtres rapides :
Dna sequencing Photos Stock & Des Images

RMBXN6DW–Le séquençage de l'ADN. Partie d'une séquence de bases d'ADN lire générées par un séquenceur automatique.

RF2A71HK0–Code de l'ADN, séquence numérique binaire Senger en stockage. 3D Illustration d'une méthode de séquençage de l'ADN.

RF2C440YK–Mains du scientifique portant des gants chirurgicaux pour analyser le tableau des résultats du séquençage de l'ADN

RFDPDTYC–Tube à essai contenant du liquide avec le moniteur de l'ordinateur affichant les résultats de séquençage automatisé de l'ADN

RFPXJ7CF–Le séquençage du génome, l'ADN, l'ADN, la recherche scientifique dans le laboratoire, de la médecine, de l'illustration, vecteur.

RM2BGN6HK–Séquençage de l'ADN déterminant la séquence des acides nucléiques ou l'ordre des nucléotides de base paires code génétique

RFM94ER0–Des analyses scientifiques en génétique ADN gel utilisé, la médecine légale, de la découverte de médicaments, la biologie et la médecine.

RFM1W69F–Le séquençage du génome humain. Arrière-plan sur l'objet de séquençage de l'ADN, symboles de bases nucléotidiques sur l'obscurité.

RFR32G22–Illustration vecteur d'ADN du génome humain. La structure de l'ADN 10 EPS. Concept de séquençage du génome de l'OGM et de l'édition du génome. La chimie pharmaceutique et de la recherche de l'ADN. Molécule de la biotechnologie de la connexion . L'ADN du génome humain crispr.

RME82F2N–Tubes Eppendorf sur des graphiques montrant les résultats d'ADN (acide désoxyribonucléique) l'ordonnancement.

RMC12K4T–Le séquençage de l'ADN. X-ray image d'un gel avec des bases nucléotidiques de l'ADN (A,C,T,G) séquencés. Méthode de Sanger.

RFEBJWF2–Scientist holding en face de gel d'ADN des échantillons pour faire des essais en laboratoire

RFEWYPB0–Arrière-plan scientifique sur le thème de l'analyse de l'ADN, pipette multicanaux et la plaque de réaction de l'espace pour votre texte.

RMACDE33–L'analyseur génétique ADN criminalistique qui peuvent effectuer des tâches telles que des liens et de l'ordre dans l'analyse de l'ADN. Nebraska State Crime Lab.

RFKHW7K6–La recherche génétique, la pipette et des échantillons d'ADN sur l'adn autoradiogram illustrant la recherche en sciences du vivant et la modification génétique

RFEJ2HG2–Les scientifiques ont étudié l'ADN gel qui est utilisé dans la génétique, la médecine, la biologie, la recherche et la médecine légale. pharma

RFM1W696–Le séquençage du génome humain. Arrière-plan sur l'objet de séquençage de l'ADN, symboles de bases nucléotidiques sur l'obscurité.

RF2C2KGCA–Méthode de séquençage de l'ADN. Illustration 3D, boucle transparente, image d'arrière-plan, concept scientifique.

RFED6NFK–Des puces à ADN, puces à ADN ou biopuce, gamme de spots d'ADN nano attaché à une surface de verre pour mesurer les niveaux d'un grand nombre de

RFPXJ7CC–Le séquençage du génome, l'ADN, l'ADN, la recherche scientifique dans le laboratoire, de la médecine, de l'illustration, vecteur.

RMC12K51–Le séquençage de l'ADN. Points aux bandes représentant scientifique bases nucléotidiques (A,C,T,G) dans une radiographie d'un gel. Méthode de Sanger.

RFKPM3W3–Arrière-plan scientifique avec des outils pour l'amplification et le séquençage de l'ADN. DOF peu profondes, la plupart de l'image est floue. Cette image est tonique. L'espace pour votre

RF2C44F71–Mains du scientifique portant des gants chirurgicaux pour analyser le tableau des résultats du séquençage de l'ADN

RFKR6NW5–Arrière-plan scientifique avec des molécules d'ADN à partir de l'eau sur le noir. Le rendu 3D

RF2C2KHX1–Code de l'ADN, séquence numérique binaire Sanger en stockage. 3D Illustration d'une méthode de séquençage de l'ADN.

RMC12K4P–Le séquençage de l'ADN. X-ray image d'un gel avec des bases nucléotidiques de l'ADN (A,C,T,G) séquencés. Méthode de Sanger.

RF2H5XX5K–Image abstraite de l'ADN des codes génétiques. Image de concept à utiliser comme arrière-plan. Illustration 3D.

RF2XA4DGB–Gros plan d'une pipette laissant tomber un échantillon sur une boîte de Pétri avec un gel de séquençage d'ADN coloré en arrière-plan.

RFTTKGYE–Close-up of scientist holding par gel d'ADN des échantillons pour faire des essais en laboratoire

RMECE770–ADN coloré double hélice – génétique, biologie moléculaire et biotechnologie – illustration symbolisant la génétique, la biologie moléculaire et la biotechnologie

RF2C446E0–Mains du scientifique portant des gants chirurgicaux pour analyser le tableau des résultats du séquençage de l'ADN
RFHG92P2–Les tests génétiques de l'ADN et l'icône de concept avec des mots sur un écran et d'un médecin de toucher un bouton, isolé sur fond blanc

RMC12K56–Le séquençage de l'ADN. Scientist holding une radiographie d'un gel avec des bases nucléotidiques de l'ADN (A,C,T,G) séquencés. Méthode de Sanger.

RFHT9NPJ–La chaîne de l'ADN chromosomique de sang Modèle Helix structure spirale moléculaire Sciences illustration vectorielle.

RM2S19ERH–Mains robotiques manipulant le brin d'adn, génie génétique, fond jaune vif, contraste élevé, futuriste, structure moléculaire détaillée. 3D..

RFR32G10–Illustration vecteur d'ADN du génome humain. La structure de l'ADN 10 EPS. Concept de séquençage du génome de l'OGM et de l'édition du génome. La chimie pharmaceutique et de la recherche de l'ADN. Molécule de la biotechnologie de la connexion . L'ADN du génome humain crispr.

RMECE76A–ADN coloré double hélice – génétique, biologie moléculaire et biotechnologie – illustration symbolisant la génétique, la biologie moléculaire et la biotechnologie

RME82F2R–Tubes Eppendorf sur des graphiques montrant les résultats d'ADN (acide désoxyribonucléique) l'ordonnancement.

RFM0CWRF–Flacon coloré avec de la glace sèche pour la cryoconservation. Cryosample de cellules souches dans le milieu de culture avec le séquençage de l'cryoprotector CRISPR genome research l

RMC073PF–Le séquençage de l'ADN. Points aux bandes représentant scientifique bases nucléotidiques (A,C,T,G) dans une radiographie d'un gel. Méthode de Sanger.